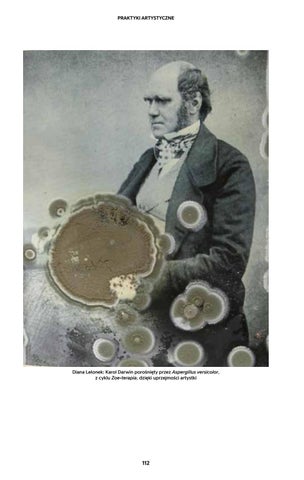

Praktyki artystyczne
Diana Lelonek: Karol Darwin porośnięty przez Aspergillus versicolor, z cyklu Zoe-terapia, dzięki uprzejmości artystki
112
Praktyki artystyczne
Diana Lelonek: Karol Darwin porośnięty przez Aspergillus versicolor, z cyklu Zoe-terapia, dzięki uprzejmości artystki
112